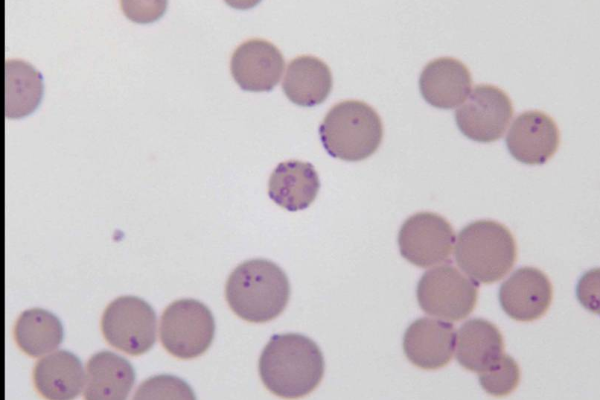

Перипневмония крупного рогатого скота
Что такое перипневмония крупного рогатого скота? Почему важно знать о перипневмонии?
Перипневмония (плевропневмания, повальное воспаление легких) - контагиозная болезнь крупного рогатого скота, характеризующаяся развитием крупной пневмонии с образованием в легких инкапсулированных очагов и возникновением серозно-фиброзного плеврита. Также перипневмония характеризуется скоплением в грудиной полости большого количества экссудата, плёнок фибрина на плевре. Перипневмонией могут болеть: крупный рогатый скот, овцы, козы, буйволы, яки, верблюды, олени. Эти животные являются основными поставщиками мясо-молочной продукции в самых разных странах мира. И, так как летальность от перипневмонии составляет около 70%, а лечение животных не рекомендуется, очень важно знать меры профилактики и предотвращения заражения поголовья животных.
Какова морфология возбудителя?
Возбудитель болезни - Mycoplasma mycoides subspecies mycoides. Возбудители имеет характерную для семейства микоплазм форму: кокковую, диплококковую, нитевидную, ветвящуюся, звёздчатую. Возбудитель проходит через бактериальной фильтры. В препаратах из культур микоплазма хорошо окрашивается по Романовскому – Гимзе а также всеми анилиновыми красками. Оптимальная температура развития возбудителя перипневмонии крупного рогатого скота 37 °C, pH 7,0. Высушивание и действие солнечных лучей на пастбище уничтожают микроб через 5-24 ч, в экссудате из грудной полости при температуре 4-8 °С он сохраняет вирулентность до 9 сут, нагревание до 60 °С убивает его в течение часа, в бульонных культурах при 37 °С гибнет через 3 нед. В замороженных легких и лимфе возбудитель может сохраняться от нескольких месяцев до года, в лиофилизированных бульонных культурах и экссудате - более 5 лет.Гидроокись натрия, хлорная известь, формалин в обычных концентрациях обезвреживают возбудителя через 3-4 ч. Дезинфекция - 1% раствор раствор лизола, 2% раствор едкого натрия карболовой кислоты, едкого калия убивают микоплазму в течение 3 – 4 часов.
Как животные заражаются?
Болезнь распространена в ряде стран Африки, встречается в Европе (Испания), Азии (Иордания, Саудовская Аравия, Китай, Индия, Монголия) и Австралии. Источник возбудителя инфекции — больные животные, особенно хронически больные, у которых могут отсутствовать типичные клинические признаки болезни. Заражение происходит аэрогенным путём даже при кратковременном контакте больных и здоровых животных. Возбудитель болезни выделяется из организма больного животного с истечением из носа, каплями слизи при кашле, реже с мочой, молоком и околоплодной жидкостью.
Как протекает болезнь? Какие особенные симптомы?
Возбудитель, попадая в лёгкие, находит благоприятную среду для своего развития на слизистых оболочках бронхов и бронхиол размножается, продуцирует в большом количестве токсин. Токсин всасывается в кровь и вызывает общую реакцию организма. Инкубационный период 2—4 недели. Различают сверхострое, острое, подострое и хроническое течение, а также атипичную форму болезни.
- При сверхостром течении резко выражены признаки поражения плевры (экссудативный плеврит) или лёгких. Дыхание затруднено, прерывисто, возникает кашель. Температуpa тела выше 41оС. Аппетит отсутствует, жвачка прекращается, развивается диарея. Животные погибают на 2—8-е сут.
- При остром течении отмечают период, характеризующийся кашлем, невысоким подъёмом температуры тела. Затем температура поднимается до 42 °С (лихорадка, как правило, постоянного и реже ремитирующего типа). Дыхание учащённое, поверхностное. Сердечный толчок стучащий, пульс слабый. Животное болезненно реагирует на надавливание в области межрёберных промежутков и позвоночника. Общее состояние животного ухудшается, отмечают потерю аппетита, снижение удоя. Кашель, вначале сухой, короткий, болезненный, затем становится сильным, глухим, влажным. Перкуссией выявляется притупление, при аускультации не обнаруживают дыхательных шумов. Поражение плевры сопровождается шумами трения, при наличии каверн в лёгких слышен звук падающей капли. Наблюдают двустороннее истечение из носовой полости. На нижней поверхности грудной клетки и конечностях появляются отёки. Отмечается также запор, сменяющийся поносом. Больные животные погибают через 14— 28 сут. Иногда процесс принимает подострое или хроническое течение.
- При подостром течении болезнь проявляется редким кашлем, диареей, лихорадкой.
- Хроническое течение характеризуется исхуданием, кашлем, периодическими расстройствами деятельности желудочно-кишечного тракта. Перкуссией и аускультацией устанавливают наличие секвестров в лёгких. Во время кашля выбрасываются гнойные хлопья. Иногда возникают отёки брюшной стенки, нижнего края шеи, конечностей. Процесс может длиться неделями и месяцами. Большинство хронически больных животных гибнет или их выбраковывают на мясо. Атипичная форма болезни проявляется непродолжительной лихорадкой, вялостью, снижением аппетита и быстропроходящем кашлем.
Какие существуют методы диагностики на данный момент?
Диагноз основан на выделение чистой культуры микоплазм из плеврального экссудата на жидких и твёрдых средах. Для прижизненной диагностики применяют серологическое реакция – РСК. При вскрытии животного характерным признаком при остром течении – мраморность лёгкого. Однако прижизненная диагностика этого заболевания достаточно затруднена. Для этого проводят контрольный убой нескольких животных и последующее их вскрытие, либо прибегают к постановке биопробы на телятах.

Какие существуют способы защиты?
Животных прививают живыми культуральнымм вакцинами. Продолжительность иммунитета после прививки до года. Лечение животных не рекомендуется. Больные животные подлежат убою.
Можно ли употреблять в пищу мясо зараженных животных?
Мясо используют в пищу людям после проварки или переработки его на варёные колбасы. Пораженные внутренние органы и забракованные части туши уничтожают. Кожи обеззараживают высушиванием.
Written by
Arina TARAN
BreedsMore
IllnessesMore
Forage cropsMore
Патологическая физиология голодания Arina TARAN
Дефицит фосфора (гипофосфатемия) Hipofosfatemi Arina TARAN
Какие бывают кормораздатчики для ферм КРС? Irina Makarova
Кормушки для овец Diana Myakisheva
Питание домашних коз: что едят, виды корма и правила кормления Alina Arslantürk
Важность минералов питании сельскохозяйственных животных Irina Makarova



















